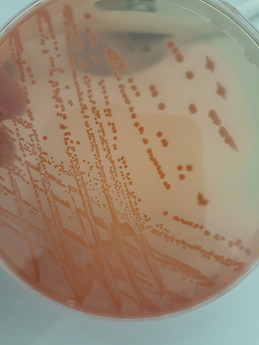
Nadia Safia Chenouf

Nadia Safia Chenouf
Nadia Safia Chenouf
- Current city:
- Algiers
- City of birth:
- Algiers
- Host university:
- UNIRIOJA
- Home university:
- UNIV-ALGER
Nadia Safia activity
Nadia Safia doesn't have any Erasmusu activity yet.